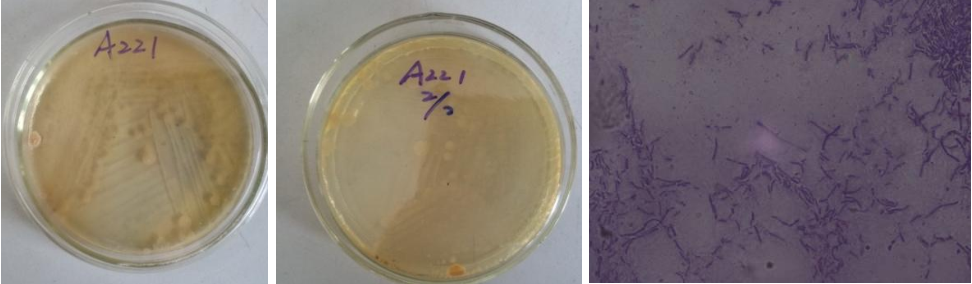

Loading...
| StrainNO | A221 |
| Classification | Streptacidiphilus |
| 16s rDNA sequence | ATTACACATTCAAGTCGAACGCCGAACCACCTCCGGGTGGGGAGGAGTGGCGAACGGGTGAGTAACACGTGGGCAATCTGCCCTG CACTCTGGGATAACTCCGGGAAACCGGAGCTAATACCGGATACGACTCTCCAGGGCATCCTGGGGGGTGGAAAGCTCCGGCGGTG CAGGATGAGCCCGCGGCCTATCAGCTGGTTGGTGGGGTGACGGCCCACCAAGGCGACGACGGGTAGCCGGCCTGAGAGGGCGACC GGCCACACTGGGACTGAGACACGGCCCAGACTCCTACGGGAGGCAGCAGTGGGGAATATTGCACAATGGGCGCAAGCCTGATGCA GCGACGCCGCGTGAGGGATGACGGCCTTCGGGTTGTAAACCTCTTTCAGCAGGGAAGAAGCGCAAGTGACGGTACCTGCAGAAGA AGCACCGGCTAACTACGTGCCAGCAGCCGCGGTAATACGTAAGGTGCGAGCGTTGTCCGGAATTATTGGGCGTAAAGAGCTCGTA GCGGCCTGTCGCGTCGGATGTGAAAGCCCGGGGCTTAACCCCGGGTCTGCATTCGATACGGGCAGGCTAGAGTTCGGTAGGGGAG ATCGGAATTCCTGGTGTAGCGGTGAAATGCGCAGATATCAGGAGGAACACCGGTGGCGAAGGCGGATCTCTGGGCCGATCTGACC TGAAGAGCAA |
| Strain Morphology Photos | |
| Morphological Description |